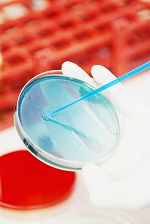

诊断试剂原辅料——尿检试纸/尿检质控液系列产品
- 百灵威科技有限公司2015年5月19日 9:08 点击:1519
|
百灵威公司凭借全球规模的化学品资源平台以及先进的研发、生产能力,长期稳定提供诊断试剂原辅料。同时结合国内市场,推出一系列尿检试纸/尿检质控液生产用原辅料。以优秀、可靠的品质,确保分析检测的灵敏度、准确性、稳定性和抗干扰性。
明星产品推荐
底物
色原
酶
分子生物学试剂
|
全年征稿 / 资讯合作
联系邮箱:kefu@labbase.net
版权与免责声明
- 凡本网注明“来源:来宝网”的所有作品,版权均属于来宝网,转载请必须注明来宝网, //www.next-search.com,违反者本网将追究相关法律责任。
- 本网转载并注明自其它来源的作品,目的在于传递更多信息,并不代表本网赞同其观点或证实其内容的真实性,不承担此类作品侵权行为的直接责任及连带责任。其他媒体、网站或个人从本网转载时,必须保留本网注明的作品来源,并自负版权等法律责任。
- 如涉及作品内容、版权等问题,请在作品发表之日起一周内与本网联系,否则视为放弃相关权利。



.jpg)
.jpg)
.jpg)
.jpg)

.png)